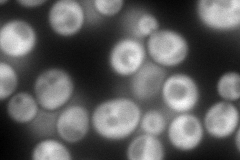
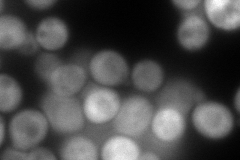
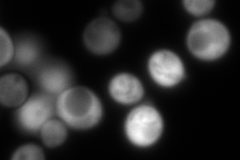

View description
Cobalamin-independent methionine synthase, involved in methionine biosynthesis and regeneration; requires a minimum of two glutamates on the methyltetrahydrofolate substrate, similar to bacterial metE homologs
Localization:
Intensity:
Fold change:
Significance:
-
C’ GFP library in SD

cytosol2103.16 -
N' NOP1pr-GFP in SD
cytosol373.185 -
N' TEF2pr-mCherry in SD
cytosol196.089 -
N' NATIVEpr-GFP in SD
cytosol670.246 -
N' TEF2pr-VC and Cyto-VN in SD

cytosol84.7662 -
C’ GFP library in SD+DTT

cytosol3135.681.49Yes -
C’ GFP library in SD+H2O2

cytosol2103.161No -
C’ GFP library in Starvation Media

cytosolN/AN/AYes -
C’ GFP library on the background of Pup2-DaMP

cytosol -
C’ GFP library on the background of CCT mutant

cytosol2161.071.02753No
